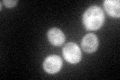
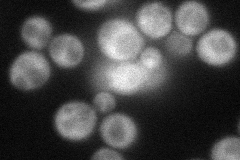
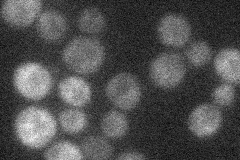
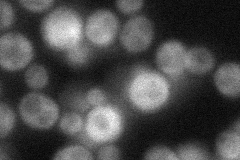
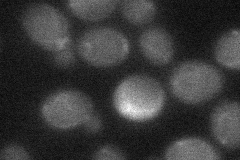
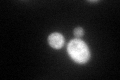

View description
Subunit of the CCR4-NOT complex, which has roles in transcription regulation, mRNA degradation, and post-transcriptional modifications; with Ubc4p, ubiquitinates nascent polypeptide-associated complex subunits and histone demethyase Jhd2p
Localization:
Intensity:
Fold change:
Significance:
-
C’ GFP library in SD
cytosol60.38 -
N' NOP1pr-GFP in SD
cytosol58.1787 -
N' TEF2pr-mCherry in SD
cytosol11.635 -
N' NATIVEpr-GFP in SD
cytosol51.4764 -
N' TEF2pr-VC and Cyto-VN in SD
below threshold28.3526 -
C’ GFP library in SD+DTT
cytosol67.961.12No -
C’ GFP library in SD+H2O2

cytosol69.371.14No -
C’ GFP library in Starvation Media

cytosol52.770.87No -
C’ GFP library on the background of Pup2-DaMP

cytosol -
C’ GFP library on the background of CCT mutant

cytosol65.75051.08882No
